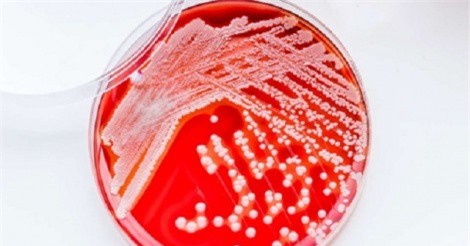
Bất ngờ với loại thuốc kháng sinh mới có nguồn gốc từ đất

Tìm kiếm: Rockefeller
Nếu có một nguyên tắc bao quát về thành công của vua dầu mỏ John D. Rockefeller thì nó được gói gọn trong câu nói sau: “Tôi thà kiểm soát chính mình còn hơn để người khác kiểm soát tôi”.
Giờ đây, bước vào thế hệ thứ 7, với gần 170 người thừa kế, gia đình này vẫn duy trì được khối tài sản đồ. Bí quyết của họ là gì?
Làm con của những vị tỷ phú giàu có nhất thế giới, họ vừa sở hữu nhan sắc vạn người mê lại vừa theo học tại các trường đại học lớn nhất thế giới.
Các nhà doanh nhân huyền thoại như John D. Rockefeller, Thomas Edison hay Steve Jobs đều sử dụng cùng một công thức này khi họ đối mặt với những trở ngại, thậm chí họ còn sử dụng những trở ngại này thành "bàn đạp" cho những tham vọng to lớn của mình.
Các nhà khoa học Mỹ phát hiện loại thuốc kháng sinh mới có nguồn gốc từ đất có thể sử dụng để chống lại nhiều bệnh nhiễm trùng khó điều trị.
Trong lịch sử nhân loại đã và đang xuất hiện nhiều bộ tộc có tập tục ăn thịt người kinh hoàng.
Đây đều là những cây thông ấn tượng, lộng lẫy nhất và là biểu tượng không thể thiếu dịp Noel ở các nước.
Đại diện Công ty TNHH Liên doanh T&A Ogilvy xác nhận ông Nguyễn Thanh Sơn đã rời ghế giám đốc từ tháng 7/2016, tức trước khi công ty tài trợ cho cuộc khảo sát nước mắm của Vinastas.
(DNVN) - Sau thời gian chờ đợi, cái tên đứng sau tài trợ cho Vinastas khảo sát chất lượng mắm đã chính thức lộ diện. Đó chính là Công ty T&A Ogilvy - một cái tên được đánh giá khá cao trong giới truyền thông.
(DNVN) - Đàn ông có một loại protein đặc biệt, trong điều kiện nhất định chặn các chuỗi não liên kết với các lo âu nên họ thường ít bị căng thẳng hơn phụ nữ.
(DNVN) - Hội đồng giải thưởng Nobel đã công bố giải Nobel y học lần thứ 106 thuộc về nhà khoa học Nhật Bản Yoshinori Ohsumi.
Những công ty không giám mạo hiểm chắc chắn sẽ bị bỏ lại phía sau các công ty dám mạo hiểm. Hãy điều khiển sự thay đổi sẽ tốt hơn là để nó điều khiển bạn”, John Marriott viết trong nhật ký của mình.
(DNVN) - Ngày 12/6 vừa qua, David Rockefeller vừa đón sinh nhật thứ 100, đồng thời cũng giữ danh hiệu tỷ phú già nhất thế giới tính đến thời điểm hiện tại.
Andrew Carnegie được mệnh danh là ông “vua ngành thép”. Điều lạ là ông chẳng biết chút gì về việc sản xuất thép. Hàng ngàn người làm việc cho ông có kiến thức về thép hơn ông rất nhiều. Bí quyết nào đã đưa ông đến “ngôi vương” của ngành này?
Chủ tịch UBND tỉnh Phú Yên khẳng định, tỉnh sẽ dồn sức cho các dự án chiến lược tạo động lực phát triển kinh tế, xã hội
End of content
Không có tin nào tiếp theo